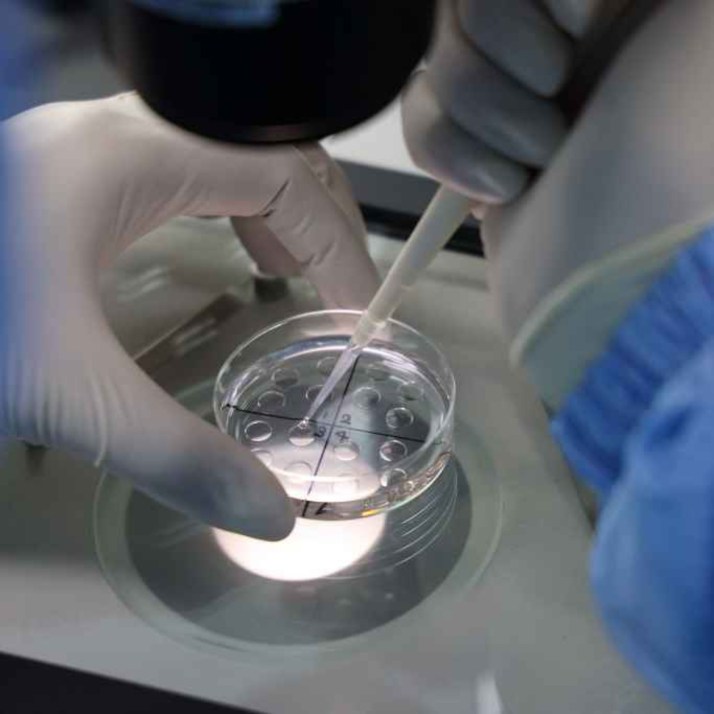

Americano
Pope vs Trump: why Trump picked a fight with Pope Leo
Donald Trump’s latest clash with the Catholic Church stunned even the most hardened veterans of culture-war X. According to the President of the United States, the Chicago-born Pope Leo XIV, the conspicuously holy spiritual leader of 1.3 billion people, is “WEAK on crime and terrible on foreign policy.” He also claimed, “If I wasn’t in
Play